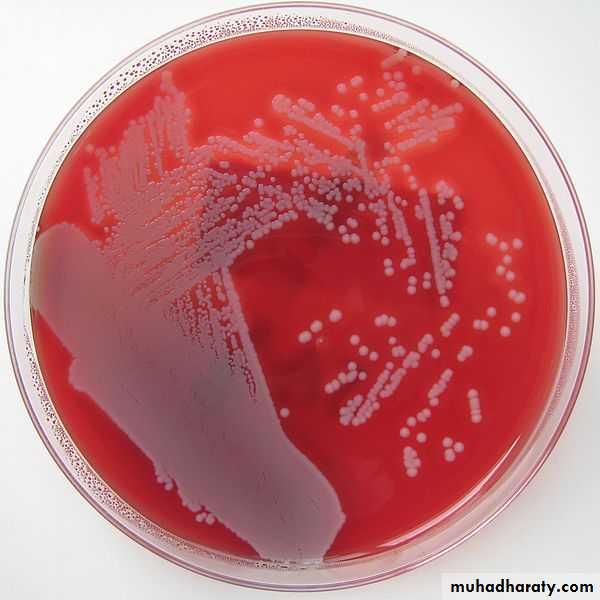

Gram positive cocci
Family MicrococcaeceaeThe gram positive cocci is the most frequent isolated from the clinical specimens.
The family micrococcaeceae include the following genera:Staphylococcus.
Micrococcus.
Planococcus.
Stomatococcus.
Genus staphylococcus:
The genus staphylococcus is composed of several spp. Many of them are a part of the normal flora.
Staph are catalase positive gram positive cocci arranged in single pairs tetrads and short chain predominantly in cluster. Non motile, non spore forming with limited capsule formation aerobic or facultative anaerobe .
Staph is initially differentiated by coagulase into
1. Coagulase positive (Staphlycoccousaureus)
2. Coagulase negative (CoNS): more than 35 spp of CoNS is identified those of clinical sigenificant are:
S. epidermidis, S. saprophyticus., S.haemolyticus.
It is the most important isolates it is responsible for infection from mild to a life threatening infections. It is recovered from any clinical sample and an important cause of hospital acquired infections. Increase drug resistance in the last decade is an important concern. It can be found in the external environment and the anterior naris in 20-50 % of adults.
Staphylococcus aureus
Peptidoglycan and tiechoic acid: it play an important role in adherence, activation of complements and chemotaxises of PMN.Protein A: has the ability to bind to the FC portion of all IgG .
Capsular polysaccharides: prevent the ingestion of the MO by the PMN (polymophnuclear leucocyte).
Virulence factors:
Enzymes :Catalase inactivate toxic H2O2 and free radicals formation in PMN.
Clumping factor: it is responsible of binding of staph to both fibrin and fibrinogens.
Coagulase (staphylocoagulase) it is found free form in the medium or cell bound it thrombin like molecule called coagulase-reacting factor (CRF) to form coagulase- CRF complex the complex resemble thrombin and directly convert fibrinogen to fibrin leading to clot formation.
Staphylokinase it causes fibrinolysis.
Hyaluronidase.
Hemolysin and leukocidin:
Toxins:
1. Enterotoxin: Heat stable exotoxin (100C for 30min) it cause food poisoning.
2. TSST1(toxic shock syndrome toxin) it is called superantigen
3. Exfoliative toxin or epidermolysin Strains produce this toxin cause staphylococcus scaled skin syndrome.
1. Skin and wound infection: S. aureus infection are suppurative. typically it cause abscess. It causes folliculitis, furuncle, carbuncle and bullous impetigo & post surgical wound infection.
2. Scalded skin syndrome (Ritter's disease) extensive exfoliative dermatitis occur in new born baby. It occur in adult only in patients with renal failure.
3. Staphylococcal food poisoning caused by staph produce heat stable enterotoxin, it cause vomiting abdominal pain with or without diarrhea NO fever.
Infection caused by S. auerus:
4. Toxic shock syndrome : it is fatal multi systemic disease and could be associated with menstruation or not associated with menstruation. Toxic shock syndrome is manifested by an abrupt onset of high fever, vomiting, diarrhea, myalgias, rash, and hypotension with cardiac and renal failure in the most severe cases. It often occurs within 5 days after the onset of menses in young women who use tampons, but it also occurs in children or in men with staphylococcal wound infections.5. S. aureus also cause bactermia,endocarditis, meningitis, osteomylitis and pneumonia.
Infection caused by S. auerus
Coagulase negative Staphlococci
The role of this mo as an etiologic agent of diseases has become increasingly evident. These mo is always isolated from the normal flora of skin. Infection is predominantly hospital acquired. Most common hospital acquired infection caused by S. epidermidis are UTIs, prosthetic valve endocarditis and intravascular catheter and CSF shunt infection. Septicemia reported in immuncompromised patient.
Staphylococcus epidermidis
It is associated with UTI in young sexually active female (true urinary pathogen) but it is the commonest cause of UTI . It is rarely found on other mucous membrane or skin surfaces. In urine culture it may be found in low concentration but still considered pathogenic.Staphylococcus saprophyticus :
Sample is taken from the site after proper cleansing of the area and transport immediately without delay to avoid dryness of the sample.Microscopical examination: Direct gram stain smear to see gram positive or variable cocci arranged in single.
Pairs tetrad or clusters inside and outside the PMN.
Laboratory diagnosis:
Isolationstaph grows readily on routine culture medium particularly SBA (sheep blood agar) within 24 hr. On SBA after 18-24 hr of incubation at 35-37 C Staph aureus produce round smooth colony with hemolytic zone with golden yellow pigment.
S epidermidis produce non hemolytic white colony .
S. saprophyticus produce larger colonies only 50% produce yellow colonies.
MSA (mannitol salt agar) is good selective culture media for isolation of S. auerus. It diagnosed by mannitol fermentation .
On Identification :
Catalase differentiated staph from Streptococci.Staph differentiated from micrococci on basis of
a. oxidative fermentation reaction. Staph ferment glucose while micrococci fail to form acid under anaerobic condition.
b. modified oxidase test staph –ve, micrococci +ve.
Identification of staph auerus :
Slide coagulase :Clumping factor formerly referred to as cell bound coagulase it causes agglutination in human and rabbit serum detected by slide method.Tube coagulase: strain of Staph aureus does not produce clumping factor should be investigated for coagulase production by tube method (staphylocogulase).
Isolates do not produce clumping factor or staphylocoagulase are reported as CoNS.
Antimicrobial susceptibility :
Broth microdilution or disk diffusion susceptibility testing should be done routinely on Staph aureus isolates from clinically significant infections. Resistance to penicillin G can be predicted by a positive test for β-lactamase; approximately 90% of S aureus produce β- lactamase. Increasing resistance to alternative antibiotics is of major concern. Testing of CoNS is dependent on source and determination if the isolate is a likely pathogen. Resistance to nafcillin (and oxacillin and methicillin) occurs in about 35% of S aureus and approximately 75% of S epidermidis isolates.Isolates resistant to penicillinase resistant penicillin called methicillin resistance staph. (MRSA =S.aureus, MRSE=epidermidis).
In the past MRSA was associated with hospital acquired infection since the late 1990s, however, MRSA has been found to be associated with community acquired infections.
Oxacillin and other penicillinase- resistant penicillin such as methicillin , naficillin cloxacillin , constitutes the drug class of choice for treating staphylococcal infection . Staphylococcal resistance to the penicillinase- resistant penicillin is due to the presence of a unique penicillin binding protein (PBP2a or PBP2'). The penicillin binding protein , which has a low affinity for binding all β-lactam drugs, is encoded by mec a gene.
Methicillin resistant Staphylococci
Disk diffusion method: If disk diffusion is used the edge of the inhibition should be examined closely. The border is sharp and clear when oxacillin is susceptible organism are tested. Growth of oxacillin resistant organism " feather " or trails as the disk approach.If disk susceptibility is not clear using oxacillin salt agar screening test , use Mueller hinton agar with 4% NaCl and 6µg/ml oxacillin.
Gold standard is by detecting the mec gene by PCR.
Detection of PBP2a using latex, fluorescence technology.
All oxacillin resistant staph should be considered resistant to all β lactam drug regardless the in vitro test results.
Vancomycin remain the DOC for MRSA, but increase resistance to glycopeptides call for restrictive use of these drugs.
Identification of MRSA
Vancomycin is the drug of choice and sometimes the only drug available for serious staphylococcus infection. And thus the development of vancomycin resistance has been a serious concern.The most accurate susceptibility is done by nonautomated method. Detection of these strain should be reported to the CDC.
Vancomycin resistant staphylococci
Minor skin infections are usually treated with an antibiotic ointment such as a nonprescription triple-antibiotic mixture. In some cases, oral antibiotics may be given for skin infections. Additionally, if abscesses are present, they are surgically drained. More serious and life-threatening infections are treated with intravenous antibiotics.Several different types of antibiotics have been used to treat staph infections. The choice of antibiotic depends on the type and severity of the infection as well as drug-resistance patterns of the particular bacterial type. Some of the antibiotics that have been used to treat staph infections are cephalosporines, nafcillin ,oxacillin, rifampin and clinamycin.
Treatment of Staph infection
Combinations of antibiotics and other antibiotics can also be used.
MRSA treated with vancomycin.Treatment of vancomycin resistant staph is by the use of daptomycin